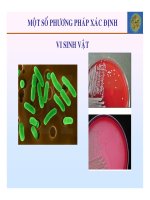
Bài giảng vi sinh vật thực phẩm   chương 6 một số phương pháp xác định vi sinh vật

Thử nghiệm một số phương pháp xác định nhanh sinh khối cho trang thái rừng nghèo tại khu bảo tồn thiên nhiên xuân liên, thường xuân thanh hóa
Bạn đang xem bản rút gọn của tài liệu. Xem và tải ngay bản đầy đủ của tài liệu tại đây (2.98 MB, 110 trang )
LỜI CAM ĐOAN
Tôi xin cam đoan đây là công trình nghiên cứu của riêng tôi. Các số liệu và kết
quả nghiên cứu trong luận văn là trung thực và chưa từng được công bố trong bất kỳ một
công trình nào khác. Mọi sự giúp đỡ cho việc thực hiện luận văn tốt nghiệp này đã
được cảm ơn và các thông tin trích dẫn trong luận văn đều đã được chỉ rõ nguồn
gốc.
Hà Nội, ngày… tháng… năm 2014
Tác giả
Đỗ Thị Hương
LỜI CẢM ƠN
Sau thời gian học tập tại Trường Đại học Lâm nghiệp, khóa học Cao học K20B Lâm
học (2012 – 2014) đã bước vào giai đoạn kết thúc. Được sự đồng ý của nhà trường và Khoa
Đào tạo Sau Đại học, tôi đã tiến hành thực hiện đề tài tốt nghiệp “Thử nghiệm một số
phương pháp xác định nhanh sinh khối cho trạng thái rừng nghèo tại khu bảo tồn thiên
nhiên Xuân Liên, Thường Xuân, Thanh Hóa”. Sau thời gian nghiên cứu, thực hiện luận
văn, với sự nỗ lực của bản thân cùng sự giúp đỡ nhiệt tình của quý thầy cô, bạn bè, đồng
nghiệp, đến nay luận văn cơ bản đã hoàn thành.
Nhân dịp này, tôi xin được bày tỏ lòng biết ơn chân thành và sâu sắc nhất tới thầy
giáo TS. Lê Xuân Trường, người đã trực tiếp tận tình hướng dẫn và giúp đỡ tôi hoàn thành
luận văn này.
Tôi xin gửi lời cảm ơn chân thành tới Ban giám hiệu Trường Đại học Lâm nghiệp,
Khoa Đào tạo Sau Đại học, Trung tâm Thực hành thí nghiệm Khoa Lâm học cùng tập thể
quý thầy cô giáo và tập thể Cán bộ viên chức trong nhà trường. Đồng thời tôi cũng xin được
gửi lời cảm ơn tới Ban giám đốc cùng toàn thể các Cán bộ viên chức của Khu bảo tồn thiên
nhiên Xuân Liên, các anh em, bạn bè, đồng nghiệp đã tạo điều kiện giúp đỡ về thời gian, thu
thập số liệu và tham gia đóng góp những ý kiến quý báu góp phần hoàn thiện luận văn này.
Sau cùng tôi xin được bày tỏ lòng biết ơn sâu sắc tới gia đình và người thân của tôi,
những người đã luôn sát cánh bên tôi, động viên, giúp đỡ tôi về mọi mặt trong quá trình học
tập và thực hiện luận văn này.
Mặc dù đã rất cố gắng trong quá trình thực hiện, nhưng vì điều kiện thời gian có hạn,
khả năng của bản thân cũng có những hạn chế nhất định nên luận văn không thể tránh khỏi
những thiếu sót. Kính mong nhận được những ý kiến góp ý quý báu của các thầy cô giáo, các
nhà khoa học và các bạn đồng nghiệp để luận văn được hoàn thiện hơn.
Xin trân trọng cảm ơn!
Hà Nội, ngày... tháng... năm 2014
Tác giả
Đỗ Thị Hương
DANH MỤC CÁC KÝ HIỆU, VIẾT TẮT
BNNPTNT
BTTN
BVNN
CBTT
CDM
DL
DLST
FAO
GDP
GEF
HC-DV
IPCC
JIFPRO
KBT
LULUCF
OTC
PHST
REDD+
TTR
UNDP
UNEF
VNCPC
VRR
Bộ Nông nghiệp Phát triển nông thôn
Bảo tồn thiên nhiên
Bảo vệ nghiêm ngặt
Cây bụi thảm tươi
Clean Development Mechanism
Du lịch
Du lịch sinh thái
Food and Agriculture Organization
Gross Domestic Product
Global Environment Facility
Hành chính – Dịch vụ
Intergovernmental Panel on Climate Change
Japan Intrerrnational Forestry of Promotion
Khu bảo tồn
Land Use, Land- Use Change and Forestry
Ô tiêu chuẩn
Phân hệ sinh thái
Reduced Emission from Deforestation and Forest Degradation
Trạng thái rừng
United Nations Development Programme
United Nations Emergency Force
Vietnam Cleaner Production Centre
Vật rơi rụng
DANH MỤC CÁC BẢNG
STT Bảng
1
2
3
4
5
6
3.1
3.2
3.3
3.4
4.1
4.2
7
4.3
8
9
10
11
4.4
4.5
4.6
4.7
12
4.8
13
4.9
14
4.10
15
4.11
16
4.12
17
4.13
18
4.14
Tên
Hiện trạng đất rừng đặc dụng theo phân khu chức năng Khu bảo tồn
Diện tích các kiểu thảm thực vật rừng đặc dụng Khu bảo tồn
Tổng hợp các loài động vật Khu BTTN Xuân Liên theo loài
Thống kê dân số và thành phần dân tộc các xã vùng đệm
Đặc trưng lâm học của trạng thái rừng nghèo
Công thức tổ thành của một số ô tiêu chuẩn theo trạng thái rừng
nghèo
Kết quả tính toán một số chỉ số xác định mức độ đa dạng tầng cây
gỗ ở các ô tiêu chuẩn của trạng thái rừng nghèo
Đặc trưng thống kê phân bố N/D của trạng thái rừng nghèo
Đặc trưng thống kê phân bố N/H của trạng thái rừng nghèo
Tổng sinh khối khô tầng cây cao của trạng thái rừng nghèo
Sinh khối cây bụi, thảm tươi và vật rơi rụng dưới tán rừng của
trạng thái rừng nghèo
Tổng sinh khối khô của trạng thái rừng nghèo (trường hợp sinh
khối tầng cây cao tính theo công thức 2.6) (cách tính 1)
Tổng sinh khối khô của trạng thái rừng nghèo (trường hợp sinh
khối tầng cây cao tính theo công thức 2.7) (cách tính 2)
Tổng sinh khối khô của trạng thái rừng nghèo (trường hợp sinh
khối tầng cây cao tính theo công thức 2.8) (cách tính 3)
Tổng trữ lượng carbon của trạng thái rừng nghèo (trường hợp sinh
khối tầng cây cao tính theo công thức 2.6) (cách tính 1)
Tổng trữ lượng carbon của trạng thái rừng nghèo (trường hợp sinh
khối tầng cây cao tính theo công thức 2.7) (cách tính 2)
Tổng trữ lượng carbon của trạng thái rừng nghèo (trường hợp sinh
khối tầng cây cao tính theo công thức 2.8) (cách tính 3)
Giá trị kinh tế do hấp thụ CO2 mang lại của trạng thái rừng nghèo
Số
trang
DANH MỤC CÁC HÌNH
STT Hình
Tên
1
2.1
Sơ đồ thiết kế ô tiêu chuẩn đo sinh khối trên mặt đất của trạng thái
rừng tại địa điểm nghiên cứu
2
3.1
3
4
5
6
7
8
9
4.1
4.2
4.3
4.4
4.5
4.6
4.7
Bản đồ thảm thực vật rừng Khu BTTN Xuân Liên, 2013
Biểu đồ phân bố N/D của trạng thái IIA
Biểu đồ phân bố N/D của trạng thái IIB
Biểu đồ phân bố N/D của trạng thái IIIA1
Biểu đồ phân bố N/H của trạng thái IIA
Biểu đồ phân bố N/H của trạng thái IIB
Biểu đồ phân bố N/H của trạng thái IIIA1
Biểu đồ tương quan H/D của trạng thái rừng nghèo
Số
trang
ĐẶT VẤN ĐỀ
Quan niệm trước đây về giá trị của rừng được xem xét chỉ dừng lại ở những giá trị
trực tiếp được sử dụng bởi con người, chủ yếu là cung cấp gỗ và các lâm sản khác. Năm
1990, Dr. Pearce đưa ra phương pháp tiếp cận mới khi phân tích các giá trị môi trường và
đa dạng sinh học của các hệ sinh thái, trong đó có các hệ sinh thái rừng. Lúc này, giá trị
mà rừng mang lại không chỉ đơn thuần là những giá trị sử dụng trực tiếp mà còn bao gồm
cả những giá trị sử dụng gián tiếp với hàng loạt những tác dụng của rừng trong việc bảo
vệ môi trường như: điều hoà khí hậu, hạn chế xói mòn và bồi lắng, bảo vệ bờ biển, điều
tiết nguồn nước và hạn chế lũ lụt,… Tuy nhiên, việc xác định các giá trị môi trường của
rừng hiện nay chưa thật đầy đủ và chưa đánh giá được hết giá trị thực tế mà rừng đem lại.
Hiện nay, biến đổi khí hậu toàn cầu đang là mối đe doạ chung của toàn nhân loại.
Sự gia tăng nồng độ khí nhà kính trong khí quyển là nguyên nhân chủ yếu gây ra hiện
tượng trên, làm cho trái đất nóng lên, các hiện tượng thời tiết cực đoan như: hạn hán, lũ
lụt,… xảy ra với tần xuất và cường độ ngày càng tăng, gây ảnh hưởng không nhỏ tới đời
sống của con người ở nhiều quốc gia, đặc biệt là những nước đang phát triển. Vì vậy, giải
pháp ứng phó với biến đổi khí hậu được rất nhiều quốc gia trên thế giới quan tâm. Các
nghiên cứu về diễn biến khí hậu cho thấy rằng giữa nồng độ khí CO2 trong khí quyển với
sự dao động chu kỳ nhiệt trên trái đất có mối quan hệ trực tiếp với nhau. Theo Tổ chức
liên chính phủ vì biến đổi khí hậu (IPCC) thì CO2 chiếm đến 60% nguyên nhân của sự
ấm lên toàn cầu, nếu nồng độ CO2 tăng lên gấp đôi sẽ làm gia tăng nhiệt độ trung bình
của mặt đất lên 2,80C/năm [26].
Trong nhiều năm qua, thực vật được xem là một giải pháp thiết thực nhằm ứng
phó với biến đổi khí hậu được các nhà khoa học nghiên cứu với mục đích góp phần làm
giảm đáng kể lượng khí CO2 ngoài bầu khí quyển, thông qua quá trình quang hợp của nó.
Bởi vậy, việc nghiên cứu khả năng hấp thụ cacbon của các loài thực vật là rất cần thiết.
Trong khi đó, rừng lại là một tổ chức phức tạp được tạo bởi nhiều loài thực vật khác
nhau. Như vậy, giá trị của rừng lại được xem xét và công nhận thông qua khả năng lưu
giữ và hấp thụ cacbon. Chính điều này đã góp phần nâng tầm giá trị của các khu rừng lên
ngưỡng cao hơn.
Hiện nay ở nước ta đã có không ít những công trình nghiên cứu lượng hóa sinh
khối và khả năng tích lũy cacbon của rừng, tuy nhiên các công trình này mới chủ yếu chỉ
thực hiện cho đối tượng rừng trồng. Trong khi đó, rừng tự nhiên lại là đối tượng có cấu
trúc phức tạp hơn nhiều nên việc tiến hành những nghiên cứu về sinh khối và trữ lượng
cacbon gặp không ít những khó khăn. Bởi vậy mà cho tới nay đối tượng rừng này vẫn ít
được quan tâm nghiên cứu, do đó việc cung cấp những cơ sở khoa học cũng như thực tiễn
cho việc lượng giá khả năng lưu giữ cacbon của rừng tự nhiên ở Việt Nam là chưa thực
sự đầy đủ. Xuất phát từ những lý do nêu trên, tôi quyết định thực hiện đề tài “Thử
nghiệm một số phương pháp xác định nhanh sinh khối cho trạng thái rừng nghèo tại
khu bảo tồn thiên nhiên Xuân Liên, Thường Xuân, Thanh Hóa”.
CHƯƠNG 1
TỔNG QUAN VẤN ĐỀ NGHIÊN CỨU
1.1. Nghiên cứu về sinh khối thực vật
Sinh khối được xác định là tất cả chất hữu cơ ở dạng sống và chết (còn ở trên cây)
ở trên hoặc ở dưới mặt đất [26]. Sinh khối được xem như một chỉ tiêu để đánh giá sức sản
xuất của thực vật và cũng là một chỉ tiêu đánh giá năng suất sinh học của thực vật.
Thực vật có khả năng quang hợp đã hấp thụ CO2 và thải lượng O2 tương ứng vào
môi trường, đồng thời tích lũy sinh khối ở dạng carbon. Do đó, nghiên cứu sinh khối thực
vật là cần thiết, đây là cơ sở xác định lượng carbon tích lũy và từ đó đánh giá khả năng
hấp thụ CO2 của thực vật, cung cấp thông tin quan trọng giúp các nhà quản lý đánh giá
chất lượng cũng như sửdụng hiệu quả hệ thực vật, tham gia thị trường carbon, làm cơ sở
cho chi trả dịch vụ môi trường. Qua đó, hạn chế tàn phá rừng.
1.1.1. Nghiên cứu sinh khối thực vật trên thế giới
Christensen (1997) [41] đã nghiên cứu sinh khối của rừng Đước ở rừng ngập mặn
đảo Phuket trên bờ biển Tây, Thái Lan. Kết quả nghiên cứu đã xác định được tổng lượng
sinh khối trên mặt đất ở rừng 15 tuổi là 159 tấn sinh khối khô trên một ha. Lượng tăng
trưởng hàng năm tính cho toàn bộ thân, cành, lá và rễ khoảng 20 tấn/ha/năm. Tổng năng
suất sinh khối khô là 27 tấn/ha/năm. Nghiên cứu cũng đã so sánh lượng vật rụng của rừng
ngập mặn và rừng mưa nhiệt đới thì thấy lượng vật rụng hàng năm của rừng ngập mặn
cao hơn so với rừng mưa nhiệt đới do rừng ngập mặn nhỏ tuổi hơn và sinh trưởng nhanh
hơn.
Isagi.Y, Kawahara. T, Kamo. K và Ito. H (1997) đã nghiên cứu sản lượng và chu
trình carbon của loài tre Phyllostachys pubescens, kết quả cho thấy: Sinh khối thân
116,50 tấn/ha, sinh khối cành 15,5 tấn/ha, sinh khối lá 5,9 tấn/ha và tổng sinh khối 137,9
tấn/ha. Sinh khối thân rễ 16,7 tấn/ha và sinh khối rễ 27,9 tấn/ha. Năng suất 32,8 tấn
C/ha/năm, thân: 9,79 tấn C/ha/năm, cành: 1,63 tấn C/ha/năm, lá: 4,45 tấn C/ha/năm [].
Michael S và Ross (1998) [50] đã nghiên cứu sinh khối và năng suất trên mặt đất
của các quần thể rừng ngập mặn ở vườn Quốc gia Biscayne, Florida (USA) từ sau cơn
bão Andrew xảy ra năm 1992, kết quả phân tích cho thấy: Cấu trúc tự nhiên của quần thể
giữ vai trò quan trọng trong việc chống bão của hệ thống rừng ngập mặn, đặc biệt kích
thước và sự phân bố của các bộ phận cấu thành sinh khối.
Akira và cs (2000) [33] qua nghiên cứu sinh khối và kích thước rễ dưới mặt đất
của Dà vôi (Ceriops tagal) ở Nam Thái Lan kết quả cho thấy: Tổng sinh khối là 137,5
tấn/ha và tỉ lệ sinh khối trên mặt đất và rễ là 1,05. Trong đó sinh khối thân được 53,35
tấn/ha, lá được 13,29, rễ được 1,99 tấn/ha và dưới mặt đất là 87,51 tấn/ha.
Kumar B. M, Rajesh G và Sudheesh K. G (2005) đã nghiên cứu sinh khối trên mặt
đất và hấp thụ chất dinh dưỡng của Bambusa bambos(L.) Voss ở khu vườn Thrissur,
Kerala, miền Nam Ấn Độ. Kết quả nghiên cứu cho thấy: Sinh khối trên mặt đất trung
bình là 2.417 kg/bụi và trung bình mỗi ha là 241,7 tấn/ha. Sinh khối tích lũy cao nhất là ở
thân tươi (82 %), tiếp theo gai và lá (13 %), thân cây chết chiếm khoảng 5 % trong sinh
khối. Thiết lập được phương trình tương quan giữa số lượng cây, sinh khối khô thân và
tổng sinh khối cụm với đường kính (DBH) như sau:
Y= -3225,8 + 1730,4*DBH (R2 = 0,83; n = 8; p < 0,001)
ln Y1= 4,298 + 2,647*ln DBH (R2 = 0,82; n = 8; p < 0,001)
Yn = -12,23 + 37,281*DBH (R2 = 0,80; n = 106; p < 0,0001)
Trong đó:
Y: Tổng sinh khối mỗi cụm,
Y1: Sinh khối khô của thân,
Yn: Sốlượng cây.
Thành phần dinh dưỡng NPK khác nhau giữa các loại mô, cao nhất ở thân tươi,
tiếp theo lá + cành và thân chết. Trung bình N, P và K hấp thụ mỗi cụm tương ứng là
9,22 kg; 1,22 kg và 14,4 kg. Sinh khối tích tụ trên vật rụng sàn rừng trung bình 909 g/m2
tương ứng với lượng N, P, K lần lượt là 48,15 kg/m2; 3,67 kg/m2 và 41,98 kg/m2 .
Việc lựa chọn sử dụng các phương pháp xác định sinh khối là rất quan trọng. Nó
quyết định đến độ chính xác của các kết quả nghiên cứu. Trên thế giới đã có rất nhiều tác
giả xây dựng phương pháp nghiên cứu sinh khối của rừng (A.A.Molchanov, 1971;
B.B.Xmimov, 1971; A.I.Utkin, 1975; et al. , theo Yxpenxkii B.B, 1983 trong Nguyễn
Văn Thêm, 2002). Mặc dù vậy, theo N.P.Anuchin (1978), phương pháp nghiên cứu sinh
khối cây rừng vẫn còn là một trong những nhiệm vụ mới của điều tra rừng. Dưới đây là
một số phương pháp đã được các tác giả công bố trong các công trình nghiên cứu của họ:
- Công trình “Đánh giá sinh khối thông qua viễn thám” được công bố bởi P.S.Roy,
K.G.Saxena và D.S.Kamat (Ấn Độ, 1956) đã nêu tổng quát vấn đề sản phẩm sinh khối và
việc đánh giá sinh khối bằng ảnh vệ tinh.
- Xác định sinh khối bằng phương pháp dioxit carbon đã được một số tác giả như
Transnean (1926), Huber (Đức, 1952), Monteith (Anh, 1960 – 1962), Lemon (Mỹ, 1960
– 1987), Inone (Nhật, 1965 – 1968),… sử dụng cho những nghiên cứu của họ. Ở đây sinh
khối được đánh giá bằng cách xác định tốc độ đồng hóa CO2.
- Aruga và Maidi (1963) đã xác định sinh khối thông qua hàm lượng Chlorophyll
trên một đơn vị diện tích mặt đất. Đây là một chỉ tiêu biểu thị khả năng của hệ sinh thái
hấp thụ các tia bức xạ hoạt động quang tổng hợp.
- Whittaker, R.H (1961, 1966) [59] [60]; Mark, P.L (1971) cho rằng: “Số đo năng
suất chính là số đo về tăng trưởng, tích lũy sinh khối ở cơ thể thực vật trong quần xã”.
- Woodwell, G.M (1965) và Whittaker, R.H (1968) [61] đã đề ra phương pháp
“thu hoạch” để nghiên cứu năng suất sơ cấp tuyệt đối.
- Phương pháp “cây mẫu” đã được Newbuold.P.J (1967) đề nghị để nghiên cứu
sinh khối và năng suất của quần xã từ các ô tiêu chuẩn. Phương pháp này được chương
trình quốc tế “IBP” thống nhất áp dụng.
- Edmonton. Et. Al (1968) đã đề xướng phương pháp Oxygen nhằm định lượng
oxy tạo ra trong quá trình quang hợp của thực vật màu xanh, từ đó tính ra được năng suất
và sinh khối rừng.
- Phương pháp xác định sinh khối rừng dựa vào mối liên hệ giữa sinh khối và kích
thước cây hoặc của từng bộ phận cây theo dạng hàm toán học nào đó được sử dụng phổ
biến ở Bắc Mỹ và Châu Âu (Whittaker, 1966) [60]; (Tritton và Hornbeck, 1982); (Smith
và Brand, 1983). Theo Grier và cộng sự (1989), Reichel (1991), Burton V. Barner và
cộng sự (1998) [38] do việc thu thập rễ cây gặp nhiều khó khăn nên phương pháp này chủ
yếu dung để xác định sinh khối của các bộ phận trên mặt đất. Theo Ong J. E. và cộng sự
(1983), trong “ Cẩm nang các phương pháp nghiên cứu năng suất hệ sinh thái rừng ngập
mặn” thì việc tính toán sinh khối cây rừng trên mặt đất thường được tính gián tiếp bằng
cách xây dựng phương trình tương quan giữa D1.3 với sinh khối khô các bộ phận của cây
(Viên Ngọc Nam, 2003).
- Xác định sinh khối bằng phương pháp lấy mẫu rễ đã được các mô tả bởi các tác
giả: Shurrman và Geodewaaen (1971), Moore (1973), Gadow và Hui (1999), Oliveira và
cộng sự (2000), Voronoi (2001), McKenzie và cộng sự (2001)[49]
- Theo Catchpole và Wheeler (1992) thì bộ phận cây bụi và những cây tầng dưới
của tán rừng đóng góp một phần quan trọng trong tổng sinh khối rừng. Các phương pháp
để ước tính sinh khối cho bộ phận này bao gồm: (1)Lấy mẫu toàn bộ cây (Quadrats); (2)
Phương pháp kẻ theo đường ; (3) Phương pháp mục trắc; (4) Phương pháp lấy mẫu kép
sử dụng tương quan.
- Năm 2001, Kurniatun và cộng sự [45] đã xây dựng một hệ thống các phương
pháp cho việc thu thập số liệu về sinh khối trên và dưới mặt đất rừng nhằm phục vụ cho
công tác nghiên cứu khả năng hấp thụ carbon của rừng.
- Năm 2006, Lu đã đề cập đến ba phương pháp tiếp cận để đánh giá sinh khối là
điều tra đo đếm, sử dụng ảnh viễn thám và phương pháp tiếp cận dựa trên hệ thống thông
tin địa lý GIS. Trong đó, phương pháp điều tra đo đếm được coi là chính xác (Lu,2006)
[48], nhưng rất tốn kém và mất thời gian (De Gier, 2003).
1.1.2. Nghiên cứu sinh khối thực vật ở Việt Nam
Ở Việt Nam trong những năm gần đây, nghiên cứu sinh khối thực vật được nhiều
nhà khoa học quan tâm và đã có nhiều kết quả đáng ghi nhận, góp phần quan trọng trong
việc đánh giá, quản lý và sử dụng hiệu quả các hệ thực vật (rừng).
Lê Hồng Phúc (1996) [21] đã có công trình “Đánh giá sinh trưởng tăng trưởng,
sinh khối và năng suất rừng trồng Thông ba lá (Pinus keysia) ở vùng Đà Lạt, Lâm
Đồng”. Tác giả đã kết luận rằng mật độ rừng trồng ảnh hưởng lớn tới sinh trưởng, tăng
trưởng, sinh khối và năng suất của rừng.
Vũ Văn Thông (1998) [27] đã nghiên cứu cơ sở xác định sinh khối cây cá lẻ và
lâm phần Keo lá tràm tại tỉnh Thái Nguyên. Tác giả cũng đã thiết lập được một số mô
hình dự đoán sinh khối cây cá lẻ bằng phương pháp sử dụng cây mẫu. Theo kết quả
nghiên cứu thì dạng hàm W = a + bD1,3và LnW = a + bLnD1,3 mô tả tốt mối quan hệ
giữa sinh khối các bộ phận với chỉ tiêu sinh trưởng đường kính. Tuy nhiên, đề tài này
cũng mới dừng lại ở việc nghiên cứu sinh khối các bộ phận trên mặt đất, chưa tiến hành
nghiên cứu sinh khối rễ và lượng vật rơi.
Viên Ngọc Nam (1998) [17] trong công trình nghiên cứu sinh khối và năng suất
sơ cấp rừng Đước (Rhizophora apiculata) trồng ở Cần Giờ, thành phố Hồ Chí Minh đã
cho rằng sinh khối rừng Đước có lượng tăng sinh khối từ 5,93 - 12,44 tấn/ha/năm, trong
đó tuổi 4 có lượng tăng sinh khối thấp nhất và cao nhất ở tuổi 12; lượng tăng đường kính
0,46 – 0,81 cm/năm, trữ lượng thảm mục tích lũy trên sàn rừng 3,4 - 12,46 tấn/ha.
Viên Ngọc Nam (2003) [18] trong công trình nghiên cứu “Nghiên cứu sinh khối
và năng suất sơ cấp quần thể Mấm trắng (Avicennia alba BL) tự nhiên tại Cần Giờ, Tp.
Hồ Chí Minh” đã xác định được tổng sinh khối, lượng tăng trưởng sinh khối, năng suất
vật rụng cũng như năng suất thuần của quần thể Mấm trắng trồng tại Cần Giờ. Tác giả
cho rằng để xác định sinh khối cây rừng, các nghiên cứu về sinh khối thường dùng
phương trình hồi quy tương quan giữa đường kính hoặc chu vi thân cây ở vị trí 1,3 m với
tổng sinh khối hay sinh khối bộ phận của cây. Nghiên cứu đã mô tả mối tương quan giữa
sinh khối các bộ phận với đường kính của cây bằng dạng phương trình logW = a +
blogD1,3 và đã tìm ra phương trình tương quan giữa sinh khối và các nhân tố điều tra cho
loài Mấm trắng là: logPttsk = -0,632085 + 2,40562*logD1,3 với hệ số xác định R2 =
0,991. Theo tác giả, sinh khối tươi thân trong quần thể Mấm trắng trung bình là 70,64 %
biến động từ 69,16 % - 73,64 %, cành chiếm 15,04 % - 22,92 % và lá chiếm 7,92 % 11,33 %. Tỉ lệ sinh khối tươi trung bình của thân và cành chiếm 91,1 % trong quần thể, tỉ
lệ sinh khối của lá giảm dần theo tuổi, ngược lại sinh khối thân + cành và cành tăng dần
theo tuổi. Sinh khối khô trung bình của quần thể Mấm trắng là 118,29 tấn/ha dao động
từ79,21 - 137,18 tấn/ha.
Lê Minh Lộc (2005) [15], trong nghiên cứu về “Phương pháp đánh giá nhanh sinh
khối và ảnh hưởng của độ sâu ngập lên sinh khối rừng Tràm (Melaleuca cajuputi) trên
đất than bùn và đất phèn khu vực U Minh Hạ, tỉnh Cà Mau”, tác giả đã tiến hành thí
nghiệm trên rừng Tràm tuổi 5, 8 và 11 tại khu vực U Minh Hạ sinh trưởng trên hai loại
đất than bùn và đất phèn. Độ ngập sâu được lựa chọn là từ thấp hơn 30cm, 30 – 60cm đến
sâu hơn 60cm tương ứng với thời gian ngập là 4 tháng/năm và trên 7 tháng/năm. Phương
pháp điều tra kết hợp với phân tích so sánh đã được sử dụng trong quá trình thực hiện.
Sinh khối của rừng Tràm có thể xác định nhanh ngoài thực địa thông qua chỉ tiêu đường
kính thân cây ngang ngực (DBH) với sai số nhỏ hơn 10%, đây là chỉ tiêu sử dụng tốt
trong ước lượng sinh khối nhanh rừng Tràm ở thực địa. Tổng sinh khối phần trên mặt đất
của rừng Tràm trên đất than bùn và đất phèn có thể tính toán bằng một hàm số hoặc biểu
sinh khối đã được lập cho rừng Tràm. Tổng sinh khối (TSK) = a x DBHb. Với a = 0,258
và b = 2,352. Sinh khối (tươi và khô) của thân, cành, lá của cây Tràm sinh trưởng trên đất
than bùn và đất phèn cũng có thể xác định nhanh ngoài thực địa thông qua mối liên hệ
của chúng với DBH. Trên cùng loại đất và tuổi rừng, sinh khối rừng Tràm có sự khác biệt
rõ rệt theo độ ngập sâu. Tổng sinh khối của rừng Tràm đạt lớn nhất ở độ ngập dưới 30cm,
và kém nhất ở độ ngập trên 60cm.
Võ Đại Hải (2007) [7] đã nghiên cứu sinh khối cây cá lẻ Mỡ trồng thuần loài vùng
trung tâm Bắc Bộ Việt Nam. Kết quả nghiên cứu cho thấy: Sinh khối khô và tươi cây cá
lẻ Mỡ thay đổi theo tuổi và theo cấp đất. Cụ thể, tuổi tăng lên thì sinh khối cũng tăng lên,
ở cấp đất tốt thì sinh khối cao hơn ở cấp đất xấu. Cấu trúc sinh khối cây cá lẻ gồm 4
phần, trong đó sinh khối thân chiếm tỷ lệ lớn nhất, sau đó đến sinh khối rễ, cành và lá.
Giữa sinh khối cây cá lẻ và các nhân tố điều tra lâm phần D1,3, Hvn tồn tại mối quan hệ
chặt chẽ với nhau, mối quan hệ này được biểu thị bằng các phương trình dạng tuyến tính
đơn giản một lớp. Với các kết quảnghiên cứu thu được, có thểsử dụng để xác định hoặc
dự báo nhanh sinh khối cây cá lẻ Mỡ thông qua chỉ tiêu D1,3và Hvn, xác định sinh khối
khô thông qua sinh khối tươi, xác định sinh khối dưới mặt đất thông qua sinh khối trên
mặt đất.
Võ Đại Hải (2008) [13] đã nghiên cứu sinh khối cây cá thể Keo lai trồng thuần
loài ở Việt Nam. Kết quả cho thấy, sinh khối cây cá thể Keo lai có sự biến đổi rất lớn
theo các cấp đất và các giai đoạn tuổi khác nhau. Cấu trúc sinh khối tươi cây cá thể keo
lai chủ yếu tập trung vào sinh khối thân 49,8 %, rễ19,1 %, lá 16,5 % và cành 14,6 %.
Giữa sinh khối khô và sinh khối tươi cây cá thể Keo lai với các nhân tố điều tra lâm phần
như D1,3, Hvn, A và giữa sinh khối khô với sinh khối tươi có mối quan hệ rất chặt chẽ
với nhau. Các mối quan hệ này được mô phỏng bởi các dạng hàm mũ (y = a.xb), hàm (y =
a.bx) với hệ số tương quan cao, sai tiêu chuẩn thấp và đơn giản, dễ áp dụng. Có thể sử
dụng các phương trình này để tính toán nhanh, dự báo sinh khối Keo lai dựa vào các nhân
tố điều tra lâm phần như D1,3, Hvn, A hoặc các tính toán sinh khối dưới mặt đất từ sinh
khối trên mặt đất, từ sinh khối tươi ra sinh khối khô.
Viên Ngọc Nam (2009) [19] đã nghiên cứu sinh khối Dà quánh (Ceriops
zippeliana) và Cóc trắng (Lumnitzera racemosa Willd) tại Khu Dự trữ sinh quyển rừng
ngập mặn Cần Giờ. K/ết quả nghiên cứu cho thấy: Sinh khối khô của các bộ phận cây
Cóc trắng cá thể được sắp xếp theo thứ tự từ cao đến thấp như sau: Thân (74,44 ± 2,25
%) > cành (19,60 ± 2,05 %) > lá (5,96 ± 0,56 %). Tỉ lệ sinh khối khô của thân cây Dà
quánh (Wthk) chiếm tỷ lệ bình quân là 56,17 ± 2,7 %, sinh khối cành khô chiếm tỷ lệ
thấp hơn là 26,67 ± 2,29 % biến động từ7,9 – 32,1 % so với sinh khối thân khô. Sinh khối
lá khô chiếm tỷ lệ là 17,16 ± 1,37 % thấp nhất.
- Sinh khối khô của Cóc trắng bằng 62,63 % sinh khối tươi và sinh khối khô của
Dà quánh bằng 54,59 % sinh khối tươi. Tỷ lệ sinh khối khô so với tươi của Dà quánh
thấp hơn Cóc trắng.
- Kết cấu sinh khối khô của các bộ phận quần thể Cóc trắng được sắp xếp theo thứ
tự từ cao đến thấp như sau: Thân (76,63 ± 1,73 %) > Cành (16,79 ± 1,35 %) > Lá (6,58 ±
0,54 %) và quần thể Dà quánh được sắp xếp: Thân (56,86 ± 0,33 %) > Cành (24,26 ±
0,85 %) > Lá (18,88 ± 0,53 %).
- Tổng sinh khối khô trung bình của quần thể Cóc trắng là 46,62 ± 10,72 tấn/ha
biến động từ 0,74 đến 125,13 tấn/ha. Tổng sinh khối khô trung bình của quần thể Dà
quánh là 40,85 ± 7,22 tấn/ha biến động từ 10,43 đến 100,55 tấn/ha.
Từ những công trình nghiên cứu của một số tác giả trong nước, có thể tổng kết lại
một số phương pháp nghiên cứu sinh khối được áp dụng phổ biến ở nước ta hiện nay
gồm:
- Phương pháp lập ÔTC và xác định sinh khối thông qua cây tiêu chuẩn: Đây là
phương pháp chủ yếu, được nhiều tác giả áp dụng như Ngô Đình Quế (2005) [24], Vũ
Tấn Phương (2006) [23], Nguyễn Thị Hà (2007), Võ Đại Hải (2007, 2009) [7] [9], Cao
Huy Bình (2009),…Theo như phương pháp này thì các ÔTC được lập đại diện cho các
lâm phần rừng trồng và rừng tự nhiên về loài cây, cấp tuổi, cấp đất, lập địa,…Diện tích
ÔTC thường dao động từ 100 – 1000 m2. Trong mỗi ÔTC tiến hành đo đếm các chỉ tiêu:
đường kính thân cây (D1.3), chiều cao vút ngọn (Hvn), đường kính tán (Dtán). Sau đó tính
toán các đại lượng bình quân và từ đó lựa chọn ra cây tiêu chuẩn. Tiến hành chặt hạ cây
tiêu chuẩn, thu thập mẫu và đem mẫu về sấy khô trong phòng thí nghiệm để xác định sinh
khối khô. Từ sinh khối khô cây tiêu chuẩn sẽ tính được sinh khối tầng cây gỗ. Sinh khối
tầng cây bụi thảm tươi và vật rơi rụng được xác định thông qua việc xây dựng các ô điều
tra dạng bản.
- Phương pháp dùng biểu sản lượng: Phương pháp này đã được Nguyễn Ngọc
Lung, Nguyễn Tường Vân (2004) [16] áp dụng để tính toán khả năng hấp thụ CO 2 cho
rừng Thông ba lá ở Lâm Đồng. Theo đó, phương pháp dựa vào biểu sản lượng hay còn
gọi là biểu quá trình sinh trưởng để có tổng trữ lượng thân cây gỗ/ha cho từng độ tuổi (M
m3/ha), nhân với khối lượng khô bình quân của loài cây gỗ đó để có khối lượng khô thân
cây, lại nhân với một hệ số chuyển đổi cho từng loại rừng để có khối lượng sinh khối
khô.
- Phương pháp dựa vào mô hình sinh trưởng: Có ba dạng mô hình sinh trưởng
chính, đó là: Mô hình thực nghiệm, thống kê; mô hình động thái và mô hình tổng hợp. Có
nhiều loài cây và rừng trồng của các loài cây này đã xây dựng được biểu thể tích và biểu
sản lượng từ các mô hình sinh trưởng và quan hệ thực nghiệm ở nước ta như rừng trồng
Keo lá tram, Mỡ, Quế, Sa mộc, Thông mã vĩ (Vũ Tiến Hinh, 1999 – 2004), Thông ba lá
(Nguyễn Ngọc Lung và Đào Công Khanh, 1999), Keo tai tượng, Thông nhựa, Tếch, Bạch
đàn Urophylla (Đào Công Khanh, 2002),. Dựa trên các kết quả này kết hợp điều tra bổ
sung các số liệu các số liệu sẵn có khác như tỷ trọng gỗ, tỷ lệ sinh khối gỗ/tổng sinh khối,
có thể tính ra được sinh khối rừng trồng. Tuy nhiên những công trình nghiên cứu này đã
được thực hiện từ lâu, mặt khác lại chỉ nghiên cứu cho những vùng sinh thái cụ thể nên
trước khi sử dụng phải tiến hành nghiên cứu bổ sung và kiểm tra độ chính xác.
- Nguyễn Hoàng Trí (1986) [28], đã áp dụng phương pháp “cây mẫu” để nghiên
cứu năng suất sinh khối một số quần xã rừng Đước đôi (Rhizophora apiculata) tại vùng
ven biển ngập mặn Minh Hải trong công trình nghiên cứu “Sinh khối và năng suất rừng
Đước”. Sử dụng phương pháp “cây mẫu” của Newboul D.J (1967), Hà Văn Tuế (1994)
đã nghiên cứu năng suất, sinh khối một số quần xã rừng trồng nguyên liệu giấy tại vùng
trung du Vĩnh Phúc.
- Vũ Văn Thông (1998) khi tiến hành nghiên cứu cơ sở xác định sinh khối cây cá
thể và lâm phần Keo lá tràm tại tỉnh Thái Nguyên đã nghiên cứu và xây dựng mô hình
xác định sinh khối Keo lá tràm, lập các bảng tra sinh khối tạm thời phục vụ cho công tác
điều tra kinh doanh rừng. Cũng tiến hành nghiên cứu trên đối tượng Keo lá tràm, Hoàng
Văn Dưỡng (2000) [4], đã tìm ra quan hệ quy luật giữa các chỉ tiêu sinh khối với các chỉ
tiêu biểu thị kích thước của cây, quan hệ giữa sinh khối tươi và sinh khối khô các bộ phận
thân cây Keo lá tràm. Nghiên cứu cũng đã lập được biểu tra sinh khối và ứng dụng biểu
xác định sinh khối cây cá thể và lâm phần Keo lá tràm.
1.2. Một số phương pháp điều tra sinh khối và hấp thụ carbon trong Lâm nghiệp
Quá trình biến đổi carbon trong hệ sinh thái được xác định từ cân bằng carbon
gồm carbon đi vào hệ thống – thông qua quang hợp và tiếp thu các hợp chất hữu cơ khác
– và carbon mất đi từ quá trình hô hấp của thực vật và động vật, lửa, khai thác, sinh vật
chết cũng như những quá trình khác [26]. Phương pháp điều tra carbon và động thái biến
đổi carbon trong rừng có thể được tóm tắt thành 4 nhóm lớn (IPCC, 2000; Smith, 2004),
bao gồm:
-
Phương pháp dựa trên đo đếm các bể carbon
-
Phương pháp dựa trên đo đếm các dòng luân chuyển carbon
-
Phương pháp dựa trên công nghệ viễn thám
-
Phương pháp mô hình hóa
1.2.1. Sinh khối và hấp thụ cacbon của lớp thực vật trên bề mặt đất
Sinh khối là đơn vị đánh giá năng suất của lâm phần. Sinh khối thực vật bao gồm
cả trên mặt đất và các bộ phận dưới mặt đất là kênh chính để loại bỏ CO2 từ khí quyển
(IPCC, 2006). Mặt khác để có được số liệu về hấp thụ các bon, khả năng và động thái
quá trình hấp thụ các bon của rừng, người ta phải tính từ sinh khối của rừng. Chính vì vậy
điều tra sinh khối cũng chính là điều tra hấp thụ các bon của rừng (Ritson and Sochacki,
2003). Các phương pháp xác định sinh khối và hấp thụ carbon trên mặt đất được trình
bày ở dưới đây (Brown, 1997; McKenzie etal., 2000; Snowdon et al., 2000; Snowdon et
al., 2002):
* Phương pháp dựa trên mật độ sinh khối của rừng
Theo phương pháp này, tổng lượng sinh khối trên bề mặt đất có thể được tính
bằng cách nhân diện tích của một lâm phần với mật độ sinh khối tương ứng (thông
thường là trọng lượng của sinh khối trên mặt đất/ha). Carbon thường được tính từ sinh
khối bằng cách nhân hệ số chuyển đổi là cố định 0,5. Vì vậy việc chọn hệ số chuyển đổi
có vai trò rất quan trọng cho tính chính xác phương pháp này.
* Phương pháp dựa trên điều tra rừng thông thường
Để điều tra sinh khối và hấp thụ carbon của rừng, phương pháp đo đếm trực tiếp
truyền thống trên một số lượng ô tiêu chuẩn đủ lớn của các đối tượng rừng khác nhau cho
kết quả đáng tin cậy. Tuy nhiên, phương pháp này khá tốn kém. Ngoài ra, khi tiến hành
điều tra, các cây không có giá trị thương mại hoặc cây nhỏ thường không được đo đếm.
* Phương pháp dựa trên điều tra thể tích
Phương pháp dựa trên điều tra thể tích là sử dụng hệ sốchuyển đổi để tính tổng
sinh khối trên mặt đất từ sinh khối thân cây. Phương pháp này bao gồm ba bước:
- Tính thể tích gỗ thân cây từ số liệu điều tra.
- Chuyển đổi từ thể tích gỗ thân cây thành sinh khối và carbon của cây bằng cách
nhân với tỷ trọng gỗ và hàm lượng carbon trong gỗ.
- Tính tổng số sinh khối trên mặt đất bằng cách nhân với hệ số chuyển đổi sinh
khối (tỷ lệ giữa tổng sinh khối /sinh khối thân).
Phương pháp sử dụng hệ số chuyển đổi sinh khối – carbon đã được sử dụng để
tính sinh khối và carbon cho nhiều loại rừng trên thế giới trong đó có rừng tự nhiên nhiệt
đới.
* Phương pháp dựa trên các nhân tố điều tra lâm phần
Các nhân tố điều tra lâm phần như sinh khối, tổng tiết diện ngang, mật độ, tuổi,
chiều cao tầng trội, và thậm chí các các yếu tố khí hậu và đất đai có mối liên hệ với nhau
và được mô phỏng bằng các phương trình quan hệ. Các phương trình này được sử dụng
để xác định sinh khối và hấp thụ carbon cho lâm phần.
Nhược điểm của phương pháp này là yêu cầu phải thu thập một số lượng nhất định
số liệu các nhân tố điều tra của lâm phần để có thể xây dựng được phương trình. Tổng
tiết diện ngang, mật độ là những nhân tố điều tra dễ đo đếm. Tuổi rừng cũng có thể xác
định ở những lâm phần được quản lý tốt hoặc có thể ước lượng từ chiều cao tầng trội.
Tuy nhiên, những giá trị này thông thường không được chỉ ra ở các nghiên cứu sinh khối.
Các biến khí hậu và tính chất đất cũng có thể được sử dụng để xây dựng các phương trình
tương quan cho lâm phần, nhưng rất khó khăn để thu thập được những số liệu này.
* Phương pháp dựa trên số liệu cây cá lẻ
Hầu hết các nghiên cứu từ trước cho đến nay về sinh khối và hấp thụ carbon là dựa
trên kết quả nghiên cứu của cây cá lẻ, trong đó có hàm lượng carbon trong các bộ phận
của cây. Theo phương pháp này, sinh khối cây cá lẻ được xác định từ mối quan hệ của nó
với các nhân tố điều tra khác của cây cá lẻ như chiều cao, đường kính ngang ngực, tiết
diện ngang, thể tích hoặc tổ hợp của các nhân tố này của cây.
Y (sinh khối, hấp thụcarbon) = f (nhân tố điều tra cây cá lẻ).
Trên thế giới đã có rất nhiều nghiên cứu về sinh khối được thực hiện theo phương
pháp này, vì thế kết hợp được những thông tin có sẵn này để xây dựng các mối quan hệ
tổng thể cho lâm phần từ đó xác định khả năng hấp thụ carbon của rừng là rất quan trọng.
* Phương pháp dựa trên vật liệu khai thác
Lượng carbon mất đi từ rừng từ khai thác kinh tế được tính bằng công thức:
C = H. E. D
Trong đó H là thể tích gỗ tròn khai thác được; D là tỷ trọng gỗ (wood density) và
E là hệ số chuyển đổi từ tổng sinh khối khai thác từ rừng. Từ đó tính được sinh khối,
lượng carbon và động thái quá trình này, đặc biệt sau khai thác.
Phương pháp này thường được sử dụng để ước lượng lượng carbon bị mất do khai
thác gỗ thương mại. Vì thế nó giúp cho việc tính tổng lượng carbon của rừng và động thái
của biến đổi carbon trong rừng.
* Phương pháp dựa trên mô hình sinh trưởng
Mô hình sinh trưởng từ những biểu đồ đơn giản nhất cho đến những phần mềm
máy tính phức tạp đã và đang là những công cụ quan trọng trong quản lý rừng. Sinh khối
và hấp thụ carbon có thể được xác định bằng mô hình sinh trưởng.
Trên thếgiới đã có rất nhiều mô hình sinh trưởng đã được phát triển và không thể
tìm hiểu được phương pháp cụ thểcủa mỗi mô hình. Vì vậy cần phải xác định được
những điểm chung để phân loại mô hình. Rất nhiều tác giả đã cố gắng phân loại mô hình
theo các nhóm khác nhau với những tiêu chuẩn khác nhau. Có thể phân loại mô hình
thành các dạng chính sau đây:
- Mô hình thực nghiệm/thống kê (empirical model) dựa trên những đo đếm của
sinh trưởng và các điều kiện tự nhiên của thời điểm đo đếm mà không xét đến các quá
trình sinh lý học.
- Mô hình động thái (process model)/mô hình sinh lý học mô tả đầy đủ các cơ chế
hóa sinh, lý sinh trong hệ sinh thái và sinh vật.
- Mô hình hỗn hợp (hybrid/mixed model), kết hợp phương pháp xây dựng hai loại
mô hình trên đây để xây dựng mô hình hỗn hợp.
Cho đến nay trên thế giới đã có rất nhiều mô hình động thái hay mô hình hỗn hợp
được xây dựng để mô phỏng quá trình phát triển của hệsinh thái rừng như: BIOMASS,
ProMod, 3 PG, Gen WTO, CO2Fix, CENTURY… Mô hình nghiên cứu sinh khối và hấp
thụ carbon và động thái CO2Fix được phát triển bởi Viện Nghiên cứu Lâm nghiệp châu
Âu, đã được sử dụng cho rừng nhiều nước trên thếgiới. Kiểm tra và đánh giá sai số cho
thấy nó có thể sử dụng cho nhiều hệ sinh thái khác nhau, trong đó có hệ sinh thái rừng,
nông lâm kết hợp các vùng nhiệt đới. Mô hình này cũng đã được sử dụng độc lập hoặc
kết hợp với các mô hình khác để xây dựng các mô hình mô phỏng áp dụng cho hệ thống
điều tra sinh khối và carbon của một số nước, hoặc các khu vực, dự án ở các nước.
Mô hình CO2Fix có khả năng áp dụng cho các nước đang phát triển chưa có điều
kiện thực hiện và thu thập số liệu trên các thí nghiệm, ô định vị lâu năm. Mô hình này đã
được sử dụng độc lập hoặc kết hợp với các mô hình khác để điều tra hấp thụ carbon và
động thái qui mô lâm phần cho đến qui mô quốc gia như các nước châu Âu, Australia,
Indonexia, Costa Rica … Vì vậy có thể sử dụng mô hình này vào điều tra carbon, động
thái quá trình này ở hệ sinh thái rừng ở Việt Nam.
* Phương pháp dựa trên công nghệ viễn thám và hệ thống thông tin địa lý
Phương pháp này sử dụng các công nghệ viễn thám và hệ thống thông tin địa lý
(GIS) với các công cụ như ảnh hàng không, ảnh vệtinh, laze, rada, hệ thống định vị toàn
cầu (GPS)… để đo đếm lượng carbon trong hệ sinh thái và biến đổi của chúng. Nó
thường được áp dụng cho các điều tra ở phạm vi quốc gia hoặc vùng và cũng rất phù hợp
cho việc kiểm tra, giám sát của các dự án sử dụng đất, chuyển đổi sử dụng đất và lâm
nghiệp (LULUCF). Tuy nhiên, với qui mô dự án, đặc biệt là dự án CDM qui mô nhỏthường có ở các nước đang phát triển, diện tích đất của các chủ rừng không lớn, phương
pháp này không thích hợp lắm vì sai số lớn và không dễ thực hiện do đòi hỏi các nguồn
lực đầu vào như thiết bị xử lý, nhân lực trình độ cao...
1.2.2. Thảm khô, thảm mục trên mặt đất
Phương pháp lập ô, đo đếm và phân tích cácbon trong lớp thảm khô, thảm mục
trên mặt đất đã được phát triển một cách cơ bản và được giới thiệu bởi nhiều tổ chức
quốc tế, IPCC, FAO, Văn phòng Quốc gia về khí nhà kính Australia, Canada… và rất
nhiều các tổ chức và tác giả khác (IPCC, 1997; McKenzie et al., 2000; IPCC, 2003).
Phương pháp thích hợp để điều tra lớp thảm khô, thảm mục là, trên mỗi ô tiêu
chuẩn đo đếm ở rừng trồng, lập 03 ô tiêu chuẩn có kích thước (2 x 2m), thu lượm và cân
toàn bộ lớp thảm khô, thảm mục, tính trung bình lượng thảm khô, thảm mục trên 1m2. Từ
đó tính được lượng thảm khô, thảm mục/ha cho lâm phần.
1.2.3. Sinh khối dưới mặt đất
Sinh khối dưới mặt đất của lâm phần là trọng lượng phần rễ sống của cây. Rễ cây
chiếm một phần quan trọng trong tổng sinh khối lâm phần. Tuy nhiên, điều tra để xác
định tổng lượng rễ cây dưới mặt đất là công việc khó khăn, đòi hỏi phải tốn nhiều thời
gian, công sức. Dưới đây trình bày một số tiêu chuẩn và phương pháp xác định sinh khối
dưới mặt đất.
* Độ sâu lấy mẫu rễ
Độ sâu lấy mẫu rễ để xác định sinh khối dưới mặt đất của rừng được kiến nghị sử
dụng độ sâu 1m (tính từ mặt đất). Mức này cũng được chấp nhận trong nhiều qui trình
điều tra cácbon và động thái cácbon dưới mặt đất (IPCC, 2003).
* Xác định sinh khối rễ dưới mặt đất
Sinh khối trên mặt đất được cho là những biến dự đoán tốt nhất cho sinh khối rễ
dưới mặt đất. Ngoài ra, sinh khối dưới mặt đất còn có quan hệ chặt trẽ với nhiều nhân tố
điều tra trên mặt đất. Zianis 2004, đã tổng kết số liệu từ các nghiên cứu trên toàn cầu và
nhận thấy sinh khối rễ có mối quan hệ chặt trẽ với đường kính ngang ngực, chiều cao
cây. Sử dụng các phương trình này là phương pháp tin cậy để xác định sinh khối dưới
mặt đất của rừng. Gần đây, hàng loạt các phương trình thực nghiệm đã được xây dựng và
sử dụng trong tính toán sinh khối và hấp thụ cácbon trong đất (Brown, 1997; Snowdon et
al., 2000; IPCC, 2003).
1.3. Nghiên cứu về khả năng hấp thụ CO2 của thực vật
1.3.1. Nghiên cứu khả năng hấp thụ CO2 của thực vật trên thế giới
Rừng có vai trò quan trọng trong điều tiết lượng CO2 trong khí quyển, chúng được
ví như bể hấp thụ loại khí này. Hàng năm, nhờ quang hợp thực vật đã tạo ra trên trái đất
150 tỷ tấn sinh khối, hấp thụ 300 tỷ tấn CO2. Năng suất hập thụ phụ thuộc nhiều vào kiểu
rừng và loại cây. Rừng kín ôn đới hấp thụ CO2 khoảng 20 – 25 tấn/ha/năm, rừng mưa
nhiệt đới thường xanh hấp thụ CO2 khoảng 150 tấn/ha/năm. Các chuyên gia môi trường
đã tính toán và cho thấy để hấp thụ được lượng khí CO2 gia tăng như tốc độ hiện nay,
mỗi năm trên Trái đất phải trồng thêm 500 triệu ha rừng và tiêu tốn 200.000 – 500.000
triệu USD. Chính vì vậy, tích lũy carbon dần trở thành một trong những nhiệm vụ cơ bản
của ngành lâm nghiệp. Đây là vấn đề quan tâm không chỉ của một hay vài nước mà là
vấn đề toàn cầu (Dẫn theo Nguyễn Thị Hạnh, 2009).
Theo nguồn từ UNEF, trong chu trình carbon toàn cầu, lượng carbon lưu giữ trong
thực vật thân gỗ và trong lòng đất khoảng 2,5 Tt* (bao gồm trong đất, sinh khối tươi và
vật rơi rụng), trong khi đó khí quyển chỉ chứa 0,8 Tt. Dòng carbon trao đổi do sự hô hấp
và quang hợp của thực vật là 0,61 Tt và dòng trao đổi giữa không khí và đại dương là
0,92 Tt. Cũng theo chu trình trên, trong tổng số 5,5 Gt* - 6,6 Gt lượng carbon thải ra từ
các hoạt động của con người thì có khoảng 0,7 Gt được hấp thụ bởi các hệ sinh thái trên
bề mặt trái đất và hầu hết lượng carbon trên trái đất được tích lũy trong đại dương và các
hệ sinh thái rừng, đặc biệt là rừng mưa nhiệt đới. Một số năm gần đây các nhà khoa học
và chuyên gia kinh tế trên thế giới đã quan tâm đến việc tích tụ carbon trong rừng để làm
giảm bớt khả năng tích tụ khí gây hiệu ứng nhà kính trong bầu khí quyển (Adams et al.,
1993; Adams et al., 1999; IPCC, 1996, 2000)[57].
Rừng đóng vai trò quan trọng trong việc chống lại biến đổi khí hậu do ảnh hưởng
của nó đến chu trình carbon toàn cầu. Tổng lượng hấp thu, dự trữ carbon của rừng trên
toàn thế giới, trong đất và thảm thực vật là khoảng 830 PgC, trong đó carbon trong đất
lớn hơn 1,5 lần carbon dự trữ trong thảm thực vật (Brown, 1997). Đối với rừng nhiệt đới,
có tới 50% lượng carbon dự trữ trong thảm thực vật và 50% dự trữ trong đất (Dixon et
al., 1994; Brown, 1997; IPCC, 2000; Pregitzer and Euskirchen, 2004) [37], [44].
Rừng trao đổi carbon với môi trường không khí thông qua quá trình quang hợp và
hô hấp. Rừng ảnh hưởng đến lượng khí nhà kính theo 4 con đường: carbon dự trữ trong
sinh khối và đất, carbon trong các sản phẩm gỗ, chất đốt sử dụng thay thế nguyên liệu
hóa thạch (IPCC, 2000) [57]. Theo ước tính, hoạt động trồng rừng và tái trồng rừng trên
thế giới có tỷ lệ hấp thu CO2 ở sinh khối trên mặt đất và dưới mặt đất là 0,4 – 1,2
tấn/ha/năm ở vùng cực Bắc, 1,5 – 4,5 tấn/ha/năm ở vùng ôn đới và 4 – 8 tấn/ha/năm ở các
vùng nhiệt đới (Dixon et al., 1994; IPCC, 2000). Browwn et al. (1996) đã ước lượng,
tổng lượng carbon mà hoạt động trồng rừng trên thế giới có thể hấp thu tối đa trong vòng
55 năm (1995 – 2050) là vào khoảng 60 – 87 Gt C, với 70% ở rừng nhiệt đới, 25% ở
rừng ôn đới và 5% ở rừng cực Bắc (Cairns et al., 1997). Tính tổng lại, rừng, trồng rừng
có thể hấp thu được 11 – 15% tổng lượng CO2 phát thải từ nguyên liệu hóa thạch trong
thời gian tương đương (Brown, 1997) [37].
Subarudi và cộng sự (2004) [55] đã phân tích chi phí cho việc thiết kế và triển khai
dự án CDM tại tỉnh Cianjur, miền Tây Java, Indonesia với diện tích là 17,5 ha (đất của
các hộ nông dân). Đây là một trong những dự án CDM đã được thiết lập trong một số
tỉnh ở Indonesia và được cấp vốn bởi tổ chức JIFPRO của Nhật Bản. Kết quả cho thấy trữ
lượng carbon hấp thụ từ19,5 – 25,5 tấn C/ha, chi phí để tạo ra một tấn carbon là 35,6 –
45,9 USD. Một tấn C tương đương với 3,67 tấn CO2, vì thế giá bán một tấn CO2 là từ 9,5
– 12,5 USD. Nghiên cứu này cũng đã đưa ra được những bài học và khuyến cáo cho việc
thực hiện những dự án tiếp theo.
Pearson T. R. H, Brown. S và Ravindranath N. H (2005) [52] trong tài liệu Ước
tính các nguồn lợi carbon tổng hợp vào các dự án của GEP, do UNDP và GEF đã xuất
bản và xây dựng phương pháp nghiên cứu hấp thụ carbon dựa trên 5 bước để tiến hành.
Các bước đó là: Xác định vùng dự án, phân cấp diện tích, quyết định bể carbon đo đếm,
xác định kiểu, số lượng, kích thước và hình dạng ô đo đếm và cuối cùng là xác định dung
lượng ô đo đếm. Phương pháp nghiên cứu hấp thụ carbon được ứng dụng và tỏ ra có hiệu
quả, được ứng dụng ở nhiều nơi.
Poonsri Wanthongchai và Somsak Piriyayota (2006) [58] đã nghiên cứu vai trò
của rừng ngập mặn trong hấp thụ carbon ở tỉnh Trat, Thái Lan với phương pháp phân tích
hàm lượng carbon chứa trong sinh khối khô của cây. Kết quả cho thấy lượng carbon
trung bình chứa trong ba loài nghiên cứu (Rhizophora mucronata, R. apiculata, B.
cylindrica) chiếm 47,77 % trọng lượng khô và ở rừng nhiều tuổi thì hấp thu lượng carbon
nhiều hơn rừng ít tuổi. Lượng carbon cao nhất là loài R. apiculata 11 tuổi với 74,75
tấn/ha, Rhizophora mucronata với 65,50 tấn/ha trong khi cũng tuổi đó B.cylindrica chỉcó
1,47 tấn/ha bởi vì hai loài trên sinh trưởng tốt hơn.
Dhruba Bijaya G. C (2008) [42] đã nghiên cứu khả năng tích tụ carbon của
Dendrocalamus strictus. Kết quả cho thấy sinh khối là 5,24 tấn/ha trong đó tổng sinh
khối thân là 4,59 tấn/ha, tổng sinh khối lá là 0,69 tấn/ha và. Tổng carbon là 232,06 tấn/ha
trong đó: Carbon tích tụ trong thân là 1,52 tấn/ha, trong lá 0,14 tấn/ha, carbon rễ 0,08
tấn/ha và carbon tích lũy trong đất là 230,32 tấn/ha.
Arun Jyoti Nath, Gitasree Das và Ashesh Kumar Das (2008) [34] đã nghiên cứu
sinh khối trên mặt đất, năng suất và khả năng tích tụ carbon của rừng tre trồng tại Assam,
miền Bắc Ấn độ. Kết quả nghiên cứu cho thấy: Tổng sinh khối trên mặt đất của khu rừng
trồng trong năm 2003 là 42,98 tấn/ha và trong năm 2006 tăng lên 152,15 tấn/ha, sinh khối
trung bình là 99,28 tấn/ha. Năng suất trung bình là 42,5 tấn/ha. Carbon tích tụ trong sinh
khối trên mặt đất từ 21,69 – 76,55 tấn/ha. Carbon tích trữ trong thân chiếm 58 – 73 %
tổng số carbon tích tụ.
Bipal Kr Jan và cs (2009) [35] đã nghiên cứu tốc độ tích lũy carbon và sinh khối
carbon trên mặt đất của 4 loài cùng độ tuổi (6 tuổi) ở Ấn Độ: Shorea robusta Gaertn.f,
Albzzia lebbek Benth, Tectona grandis Lin.f và Artocarpus integrifolia Linn. Kết quả
nghiên cứu cho thấy: Tốc độ hấp thụ carbon trung bình từ môi trường xung quanh trong
mùa đông của Shorea robusta Gaertn.f, Albzzia lebbek Benth, Tectona grandis Lin.f và
Artocarpus integrifoli Linn lần lượt là 11,13 g/giờ; 11,86 g/giờ; 2,57 g/giờ và 4,22 g/giờ.
Lượng carbon tích lũy hàng năm của Shorea robusta Gaertn.f, Albzzia lebbek Benth,
Tectona grandis Lin.f và Artocarpus integrifoli Linn tương ứng là 8,97 tấn C/ha; 11,97
tấn C/ha; 2,07 tấn C/ha và 3,33 tấn C/ha. Tỷ lệ% sinh khối carbon trên mặt đất của 4 loài
Shorea robusta Gaertn.f, Albzzia lebbek Benth, Tectona grandis Lin.f và Artocarpus
Integrifoli Linn tương ứng là 44,45 %; 47,12 %;45,45 % và 43,33 % và tổng sinh khối
carbon trên mặt đất của 4 loài ước tính là 5,22 tấn C/ha; 6,26 tấn C/ha; 7,97 tấn C/ha và
7,28 tấn C/ha.
Nhìn chung, các nghiên cứu trên đều quan tâm đến khả năng hấp thụ CO2 của rừng
và cho thấy tầm quan trọng và những giá trị của rừng đối với môi trường, rừng vừa lưu
trữ vừa hấp thụ khí CO2, giảm thiểu hiệu ứng nhà kính tác động lên môi trường sống.
1.3.2. Nghiên cứu khả năng hấp thụ CO2 của thực vật ở Việt Nam
Mặc dù các nghiên cứu trong nước chưa thực sự đang dạng, chưa đánh giá được
một cách đầy đủ và toàn diện về khả năng hấp thu carbon của rừng tự nhiên và rừng trồng
nhưng những nghiên cứu ban đầu về lĩnh vực này có ý nghĩa rất quan trọng, làm nền tảng
thiết lập thị trường giao dịch carbon trong nước.
Nhận thức được tầm quan trọng trong việc hấp thụ CO2 của các hệ sinh thái rừng,
trong những năm gần đây, các nghiên cứu về khả năng tích lũy carbon của các dạng thảm
thực vật cũng đã được tiến hành nghiên cứu ở một số khía cạnh khác nhau. Ban đầu các
nghiên cứu chủ yếu tập trung vào đánh giá lượng carbon tích lũy ở rừng trồng của một số
loài cây trồng chủ yếu như Keo, Thông, Mỡ,… và nghiên cứu lượng carbon tích tụ trong
đất dưới tán rừng, carbon trong cây bụi thảm tươi dưới tán rừng và ngoài chỗ trống.
Nguyễn Tuấn Dũng (2005) [3] đã nghiên cứu lượng carbon tích lũy của một số
trạng thái rừng trồng tại núi Luốt, trường Đại học Lâm nghiệp cho hai đối tượng là rừng
trồng thuần loài Thông mã vĩ 20 tuổi và rừng trồng Keo lá tràm 15 tuổi. Kết quả cho
thấy, đối với Thông mã vĩ 20 tuổi, lượng carbon tích lũy của cây tiêu chuẩn bình quân
lâm phần là từ 78,1 – 165,5 kg/cây; với Keo lá tràm 15 tuổi thì con số này là 133,9
kg/cây. Rừng trồng Thông mã vĩ tích lũy được 75 – 115,7 tấn carbon/ha trong cây, với
Keo lá tràm, con số này là 56,4 – 95,6 tấn carbon/ha. Tại thời điểm nghiên cứu, với rừng
trồng Thông mã vĩ 20 tuổi, lượng carbon tích lũy trong vật rơi rụng là từ 2,04 – 3,62
tấn/ha, với rừng Keo lá tràm trồng thuần loài 15 tuổi con số này nằm trong khoảng 2,36 –
4,83 tấn/ha.
Cũng trong năm 2005, Ngô Đình Quế và các cộng sự [24], khi nghiên cứu xây
dựng các tiêu chí, chỉ tiêu trồng rừng theo cơ chế phát triển sạch ở Việt Nam đã tiến hành
đánh giá khả năng hấp thụ CO2 của một số loại rừng trồng chủ yếu ở Việt Nam bao gồm:
Thông nhựa, Keo lai, Keo lá tràm, Keo tai tượng và Bạch đàn Uro ở các tuổi khác nhau
cho thấy khả năng hấp thụ CO2 của các lâm phần khác nhau tùy thuộc vào năng suất lâm
phần đó ở các tuổi nhất định. Để tích lũy khoảng 100 tấn CO2/ha, Thông nhựa phải đến
16 – 17 tuổi, Keo lai 4 – 5 tuổi, Keo tai tượng 5 – 6 tuổi, Bạch đàn Uro 4 – 5 tuổi. Tác giả
đã lập phương trình tương quan hồi quy tuyến tính giữa yếu tố lượng CO2 hấp thụ hàng
năm với năng suất gỗ và năng suất sinh học. Từ đó tính khả năng hấp thụ CO2 của các
loài trên.
Vũ Tấn Phương (2006) [22] trong nghiên cứu trữ lượng carbon của thảm tươi và
cây bụi, cho thấy rằng tỷ lệ sinh khối khô/tươi của tế guột đạt 46%, cây bụi 45% và lau
lách đạt 33%. Lượng carbon được tác giả tính như sau: lượng carbon = 50% lượng sinh
khối khô. Lượng carbon trên mặt đất biến động từ 6,6 – 20 tấn/ha, trong đó lau lách có
lượng carbon tích lũy cao nhất khoảng 20 tấn/ha, cỏ chỉ và cỏ lông lợn thấp nhất khoảng
3,9 tấn carbon/ha. Từ kết quả trên cho thấy khả năng hấp thụ CO2 của lau lách cao nhất
trong các đối tượng mà tác giả nghiên cứu.